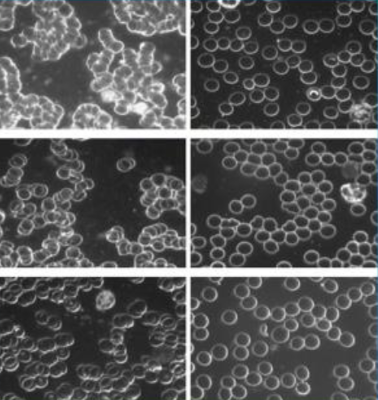

티스토리 뷰
잠만 잤을 뿐인데
피가 맑아졌다구요?
위 사진은 독일 동서의학병원 임상자료입니다.
침구를 사용하기 전, 후 변화된
생혈(피) 현미경 사진입니다.
왼쪽에 피가 엉겨져 있는 모습(피떡)과
오른쪽 맑아진 피가 동그란 모습으로 보입니다.

만성편두통 생혈변화입니다.
혈전으로 엉긴 피가
편두통의 원인임을 보여주며
건강침구를 통해
건강한 모습으로 변한 모습입니다.

대장염 혈액사진입니다.
엉겼던 혈액이 건강하게 바뀐 모습입니다.

아주대학교 임상시험 자료입니다.
어싱 매트에서 3일, 5일 생활한 생쥐의
혈소판 응집변화를 보여줍니다.
어싱 매트 사용하면서
혈소판 응집이 억제결과를 보여줍니다.
세상에!
이런 일이~
잠만 잤을 뿐인데
'세이잠'은 병들지 않는 사회를 염원합니다.
#혈전개선비결 #잠자면서혈전개선 #피떡개선사진
#혈전없애는물질 #만성편두통혈전 #만성편두통명의
#편두통잘고치는곳 #대장염혈전 #대장염잘고치는곳
#혈소판응집억제 #맨발걷기이불 #청혈이불
#혈전에좋은음식
'으뜸명의 (자연 치유럭)' 카테고리의 다른 글
| 세이잠 "회복의 기회~" (0) | 2025.10.22 |
|---|---|
| 세이잠 "건강해진 비결~" (0) | 2025.10.12 |
| 세이잠 "병을 정복하는 원리~" (4) | 2025.08.26 |
| 세이잠 "아토피 치료, 알려주세요~" (2) | 2025.08.23 |
| 세이잠 "파킨슨 변화~" (4) | 2025.08.12 |
공지사항
최근에 올라온 글
최근에 달린 댓글
- Total
- Today
- Yesterday
링크
TAG
- 복과저주 #복받는비결 #저주받는인생 #거룩한삶 #정결한삶 #순결한삶 #순종하는사람
- 천비솔 #관절 #관절염치료음식 #퇴행성관절치료음식 #관절통증치료음식 #무릎관절치료음식 #류마티스치료음식 #솔잎기름 #으뜸명의 #디스크치료음식 #협착증치료음식
- 솔잎기름 #면역력이야기 #면역력높이는음식 #면역력에좋은음식 #천비솔 #혈액순환개선음식 #암예방음식 #유방암치료음식 #으뜸명의 #생리통치료음식 #체지방분해음식 #관절염치료음식
- 솔잎기름 #안압치료음식 #녹내장치료음식 #백내장치료음식 #안구건조증치료음식 #시력좋아지는음식 #천비솔 #망막시신경에좋은음식 #으뜸명의 #눈물샘치료음식
- #솔잎기름 #담석 #담석치료음식 #담석증에좋은음식 #담석의원인 #결석치료음식 #천비솔 #으뜸명의 #뇌종양치료음식 #지방종치료음식 #요로결석치료음식 #혈전녹이는기름
- 으뜸명의다이어트 #생리불순 #생리불순치료방법 #폐경원인 #조기폐경치료방법 #요요원인 #김병찬아나운서 #저탄고지다이어트부작용 #뇌졸중치료방법
- 으뜸명의 #통풍 #통풍치료음식 #통풍원인 #통풍에좋은음식 #요산치료음식 #통풍혈액오염 #천비솔 #통풍치료법 #통풍과혈액정화 #통풍과혈액순환
- 류현진선발등판 #이달의투수상 #사이영상 #류현진승리투수 #LA다저스뉴욕메츠전
- 천비솔 #발가락염증 #염증치료음식 #상처치료음식 #항염음식 #솔잎기름효능 #젊음의비결 #젊어지는음식 #예뻐지는음식 #관절염치료음식 #류마티스치료음식 #으뜸명의
- 당뇨합병증 #망막혈관폐쇄증 #당뇨치료음식 #비문증치료음식 #망막혈관폐쇄치료음식 #시력개선음식 #당뇨합병치료음식 #으뜸명의 #혈전치료음식 #비문증치료음식 #혈액순환개선음식
- 천비솔 #변화되는중 #고혈압치료음식 #두통치료음식 #소화불량치료음식 #담적병치료음식 #혈관건강음식 #모세혈관청소 #솔잎기름 #소화불량에좋은음식 #저혈압치료음식 #으뜸명의 #솔잎기름
- 천비솔인천점 #솔잎기름과부인과질환 #생리통치료법 #자궁근종치료법 #유방암치료법 #생리불순치료법 #발기부전치료법 #유산방지음식 #자궁암방지음식
- 류현진피츠버그전 #la다저스 #무실점기록 #박찬호 #류현진경기일정 #류현진경기시간
- 아내의맛 #홍현희 #부친담도암 #암치료음식 #담도암치료음식 #난소암치료음식 #유방암치료음식 #으뜸명의 #암예방음식 #항암음식
- 멸망의길 #대만동성결혼 #소돔과고모라 #퀴어축제 #인간타락 #에이즈 #문란한성생활 #차별금지법
- 솔잎기름 #무병장수식품 #천비솔 #혈액을맑게하는음식 #모세혈관청소음식 #암예방식품 #해독식품 #으뜸명의 #생리통치료음식 #담적병치료음식 #다낭성치료음식 #혈액정화음식
- 솔잎기름 #몸이업그레이드 #천비솔체지방 #수족냉증치료음식 #담적병치료음식 #위장병치료음식 #소화불량치료음식 #고지혈치료음식 #당뇨치료음식 #으뜸명의
- 솔잎기름 #비만다이어트 #비만치료음식 #비만의원인 #다이어트음식 #지방분해음식 #천비솔 #으뜸명의 #담석치료음식 #종양치료음식 #콜레스테롤녹이는기름 #체지방분해음식
- 이지푸푸 #변비와여드름 #변비치료음식 #여드름치료음식 #여드름원인 #화농성염증원인 #화농성염증치료음식 #과민성대장증후군치료음식 #피부좋아지는음식 #으뜸명의
- 천비솔 #솔잎기름과당뇨 #당뇨치료음식 #당뇨원인 #당뇨에좋은음식 #고혈당치료음식 #저혈당원인 #지방간치료음식 #회춘식품 #회춘음식 #혈당조절음식 #으뜸명의
- 솔잎기름 #고혈압개선 #호전반응 #명현반응 #고혈압치료음식 #뇌경색치료음식 #심장경색치료음식 #동맥경화치료음식 #천비솔 #뇌출혈치료음식 #뇌졸중치료음식 #중풍치료음식 #으뜸명의 #혈관
- 천비솔치약 #세계최고보다낫네요 #솔잎기름치약 #시린이에좋은치약 #풍치개선치약 #풍치의원인 #시린이원인 #풍치치료방법 #시린이치료방법 #으뜸명의 #좋은치약
- 맘모톰수술후유증 #유방섬유선종치료법 #함몰유두 #섬유선종치료음식 #종양치료방법 #암치료방법 #물혹치료방법 #근종치료방법 #용종치료방법 #으뜸명의 #유방암치료법
- 솔잎기름 #B형간염개선 #간경화치료음식 #지방간치료음식 #B형간염치료음식 #생리통치료음식 #어혈치료음식 #으뜸명의 #천비솔 #시력좋아지는음식 #간기능개선음식
- u-20월드컵4강진출 #한국포르투갈전 #정정용 #이강인 #폴란드 #죽음의조 #조영욱 #이강인골 #조영욱골 #김정민골
- 솔잎기름 #디스크원인과치유 #디스크치료음식 #허리통증치료음식 #척추협착증치료음식 #허리디스크치료음식 #천비솔 #으뜸명의 #관절염치료음식 #고관절치료음식
- 자궁적출후유증 #물혹치료음식 #자궁근종치료음식 #자궁내막증치료음식 #자궁선근증치료음식 #생리통치료음식 #만성피로치료음식 #으뜸명의 #자궁건강에좋은음식
- 장수노인 #98세 #장수식품 #신선의음식 #생존연령 #건강연령 #고혈압치료음식 #당뇨치료음식 #암예방음식 #치매예방음식 #중풍예방음식 #으뜸명의 #솔잎기름
- 이지푸푸 #빈뇨와변비 #변비치료음식 #빈뇨치료음식 #야간빈뇨치료음식 #요실금치료음식 #생리통치료음식 #솔잎기름 #천비솔 #솔잎기름싸게사는곳 #천비솔싸게사는곳 #으뜸명의
- 솔잎기름 #값진보약 #위장병치료음식 #담적병치료음식 #소화불량치료음식 #부종치료음식 #변비치료음식 #여드름치료음식 #이지푸푸 #심장병치료음식 #심근경색치료음식 #으뜸명의
| 일 | 월 | 화 | 수 | 목 | 금 | 토 |
|---|---|---|---|---|---|---|
| 1 | 2 | 3 | 4 | 5 | 6 | 7 |
| 8 | 9 | 10 | 11 | 12 | 13 | 14 |
| 15 | 16 | 17 | 18 | 19 | 20 | 21 |
| 22 | 23 | 24 | 25 | 26 | 27 | 28 |
글 보관함